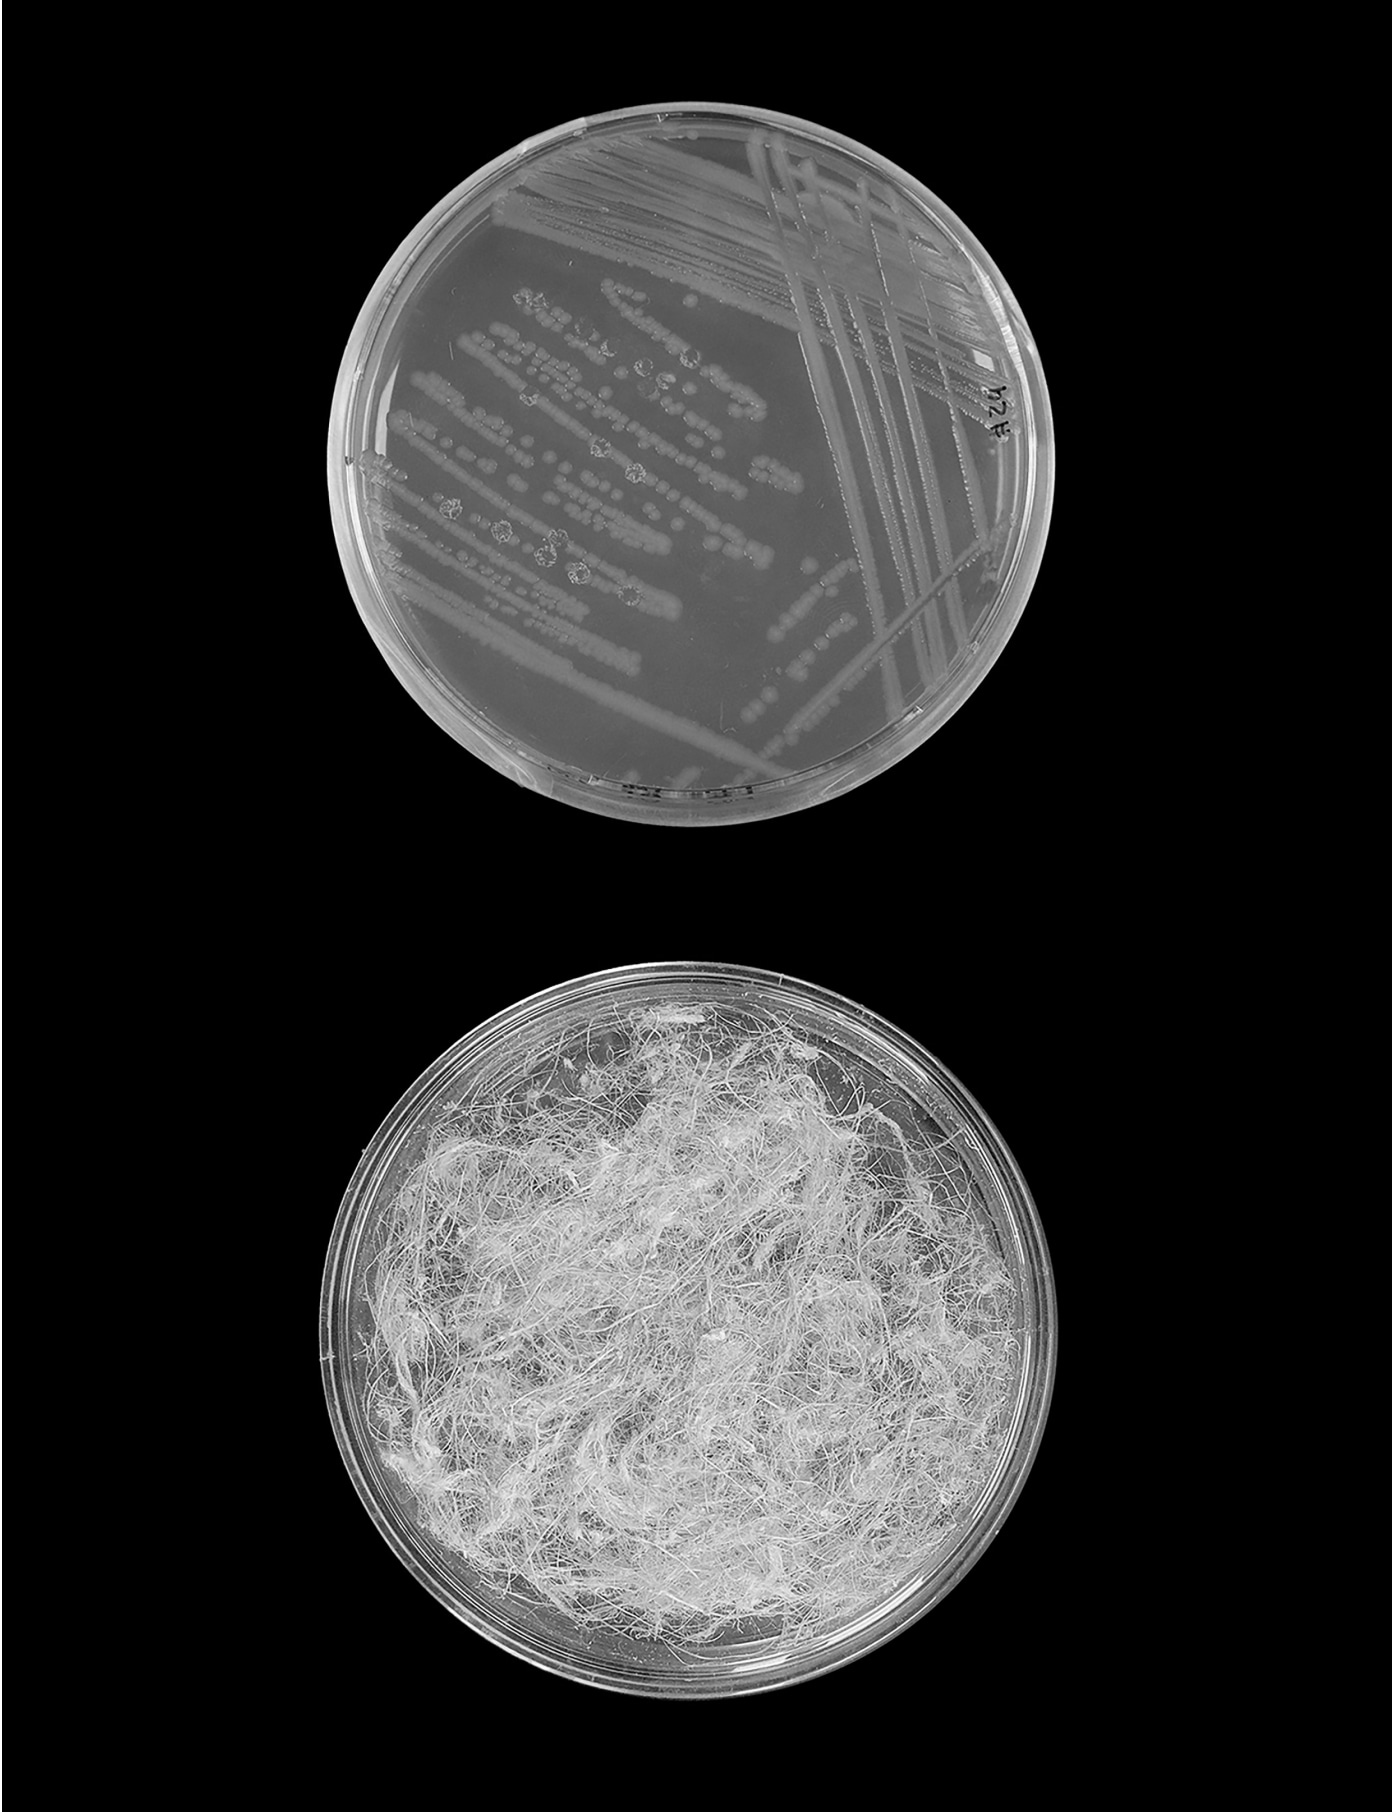

ClimaFibre
Jess Redgrave
Sunflowers can help to reduce our dependence and the environmental damage of cotton in the fashion industry. Jess Redgrave is working on a high-quality new material using residual flows from the cultivation for sunflower oil and sunflowers that grow as an intermediate crop in regenerative food cultivation. The entire flower can be used for textile fibers, pigments and a waterproof coating for, say, a raincoat.
The fast fashion industry is not sustainable for the planet. We use more land than we need and produce heaps of waste due to the high volumes of throw-away clothes produced. The chemical materials used in, for instance, dying are polluting our waters. Cotton accounts for roughly 22% of the global fibre market. Although cotton is a natural product that makes a quality fabric, its high demand has made it a monocrop. The production of cotton requires so much water and pesticides, that it is severely damaging local ecosystems and communities. Sunflowers, on the other hand, can be grown locally in regenerative systems without fertilizer and contribute to biodiversity above and below the ground.
We spoke to Jess about how new fibers made from sunflowers can contribute to more diversity in the world of textiles, and how you can make a difference as a fashion designer.


Photography: ClimaFibre
Film: Blickfänger
Hi Jess, let’s start with you, as a person and as a designer, what drives you?
The creative part has always been there for me, I’ve always loved art and design and dreamt of creative career. In the early 2000s, when I was an undergrad, a creative career as a fashion designer was considered a very glamorous role. I graduated and started working for a lot of major high street brands. In the beginning it was all very exciting, but gradually I found out that it wasn't as creative as I initially thought. I also have a big love for nature and I got fed up with how my designs for this fast fashion industry were destroying the planet.
You say the fast fashion industry has a very negative impact on the planet. Can you give us some context? What do you think could be done better?
Working in the fashion industry definitely opened my eyes. I was working a lot of hours to churn out very generic designs. The demand for more was ever increasing and the trends became repetitive. I saw how damaging this was on the planet. Lots of work and energy go into producing a single garment, and the sheer volume of clothing produced was shocking. It saddened me that most of it would end up in a landfill. Many garments were made from polyester, contaminating ecosystems with microplastic pollution. But, also, the ones in cotton made me realise how disruptive the industry is. Cotton is a natural plant and is widely used for fibre making. It’s a great plant, it's very versatile, but because it is so great, we just depend on it too much. The ever-increasing demand has led to cotton becoming a monocrop, which has a negative impact on the surrounding ecosystems. It requires a lot of water and the high volumes of pesticides and fertilizers decrease biodiversity.
After experiencing all this, I realized I wanted to use my skills to make things better. I left the fast-fashion industry and enrolled in the Material Futures Master at Central St. Martins. There, I started looking at what fibre crops actually help creating healthy soil. I got interested in regenerative farming. That's where I came across sunflowers.
Regenerative farming basically means you make the soil better for the generations that come after you, right?
Yes, exactly. And I learned that one method of working regeneratively is by using ‘break crops’. These are ‘in between crops’ that you can plant as part of a rotation, which leaves the soil in a better condition and can help increase the yield of the following crop. It reduces the amount of pesticides, fungicides and fertilisers needed. Using break crops can improve the soil structure and prevent topsoil from getting washed away. I started by looking at what crops were regenerative and discovered that sunflowers are really good for the soil. They're phytoremediators, which means they can even clean it up. They take out heavy metals that are left over from over fertilization. They can fix nitrogen from the air, store carbon and generally improve the soil. The primary use for break crops is to restore the soil, but if they can also be used as an additional source of revenue for the farmers, that’s even better - a win-win for farmers and the soil!
If you have something that is well designed and aesthetically pleasing, you can reach more people and you can probably do more good.
So, you use sunflowers as the starting point of a new material. Can you tell us what your concrete solution is, what is the product you are designing?
So, I decided to make textiles from these ‘break crop’ sunflowers. I explored the whole sunflower plant, started looking at the fibre and getting fibre from the stem. I also wanted to see what else I could get from the flowers. I started using the petals to make pigments and the seeds to make a hydrophobic coating. I used the inner disc flowers of the younger plants and the leaves as well. I made fibre, extracted pigments and developed a hydrophobic coating all from sunflowers. Right now, I am still working in a little petri dish. And I've done tests on the hydrophobic coating, and they work. Now it is a case of standardizing the process so we can look at how to scale it.
Change can come by touching people's hart. Do you agree? How do you make people love this product that is still in a research phase?
Actually, aesthetics is a big part of my work. I want to make something that's aesthetically pleasing, without it ruining the planet. Thinking carefully about the form and the look of the product is a key factor in driving sustainability. If you have something that is well designed and aesthetically pleasing, you can reach more people and you can probably do more good. I think that's probably one of the most important things design can do: to get across important research in a way that's accessible for everyone.
That is why I designed a product: a raincoat entirely made from the sunflower material. It will have the same appeal as a traditional wax jacket, but without the heavy finishx. Because I’m working with a rotational crop, there is only so much material I can make without damaging the planet. So I want it to be a useful jacket you keep for a long time and then hand down.


You are prototyping a raincoat completely made of sunflowers. How do you think about growth and circularity? How do you scale-up, while remaining sustainable?
The part of the project I’m most excited about now is the method of making fibre of the stem using enzymes. This is called ‘retting’. Retting is done either in water, which is not that great for the planet. Or there is a technique called ‘dew retting’, which is sustainable but takes quite a long time. The good news is that this process can be mimicked in a lab. This is called “enzymatic retting” and is now championed as one of the most environmentally friendly processes. Enzymes can be taken from bacteria or fungi that are found in the soil. They can be applied to break down any unwanted plant matter from the stems and leave you with the cellulose fibres, which can then be spun into a yarn.
I use this method, and, in my case, it reduces the time from stem to fibre from up to six weeks or more, down to only six days or less. This is promising, however I’m still in the experimental stage. I hope I can keep using this method when upscaling. It’s already been explored with flax and hemp, but there are currently no facilities to test this at scale in the UK. A similar sort of process is already used in juice manufacturing companies. So, it should be doable to apply it to textiles.
The coating I have developed is made from a byproduct of the sunflower oil industry and contains no nasty chemicals. The coating can be sprayed on, so looks promising for scaling! I’m still working on perfecting the formula but hope that this could become a replacement for current coatings that contain harmful PFAS (Flurocarbons).
Ok, you are about to upscale your lab tests to make sunflower yarn in a sustainable way. But making 100% sustainable choices is difficult in practice, one choice sometimes limits the other. What are the biggest dilemmas for you in this process?
I have this vision that I want it all to happen within the UK.
I envision local production here in the UK, but I see a dilemma when it comes to the availability of the ‘break crop’ sunflowers. It’s a seasonal product: how does that relate to a possible need for a more constant flow of material when you start upscaling? At what point does that become unsustainable?
To do the maths, I firstly need to standardize how much fibre I can get per stem. Then we can predict how much fibre can come from one field of sunflowers and calculate how many raincoats we can make of that.
There’s a lot of variables that need to be considered, so I don’t have all the answers yet and these are only things that one can find out in practice. I have this vision that I want it all to happen within the UK. And what format that takes is exciting to find out.
Another thing I encounter, is whether I want to focus on my own invention and build a business out of it, or if I prefer to collaborate with established companies and share my business. I found it quite hard to work on my own as I’m a sociable person. I find being a solo founder and having no one to bounce ideas off, a bit tricky.

You say that being a solo-founder is sometimes difficult. Can you explain that a bit more?
I think it goes back to being open to people and being curious. You never know what someone can say, can spark or can do. If you're facing a problem in the design process, it can be good to talk about it. Because then unexpectedly someone could provide a solution that's really helpful. But when you're on your own, it's easy to become too focused on your own project, losing a broader picture. I learned that sometimes only by speaking to other people, you realize what you need to do to bring things further.
As an entrepreneur, how do you see the future of ClimaFibre? And what does it take to get there?
Well, I'm hoping it will be a real product and yeah, I want it to be sold in Selfridges! To be honest, my focus is on the material but in the end, I am still a designer. With the raincoat I want to show an aesthetically pleasing applied version of the material. In a few years I hope we will have a production line completely within the UK, with the aim of diversifying the fibre crops we can grow here. Following that, I also would like the pilot plant to go elsewhere in the world, adapting the fibre crops to local ecosystems.
I recently got a grant that will help me to get from my lab proof of concept to a commercial proof of concept. I already have a network of people and companies that are interested in getting the product further. To get them working on it too, I again need additional funding.
We're not going to solve any issues by staying really fixed in our mindset.
To the funders and all your potential customers wearing raincoats made of sunflowers: if you could mention one thing, what is the most important message you want to get across?
That would be to encourage people to be curious. Don't settle for what's out there. Don’t always believe something you've been told is sustainable or regenerative, but question things a bit more. I think that's a very important thing to do within sustainability. We're not going to solve any issues by staying really fixed in our mindset. Explore things, talk to new people. You never know what doors can open and opportunities you will find. Try something new, it’s really exciting!
Instagram: @jess_redgrave